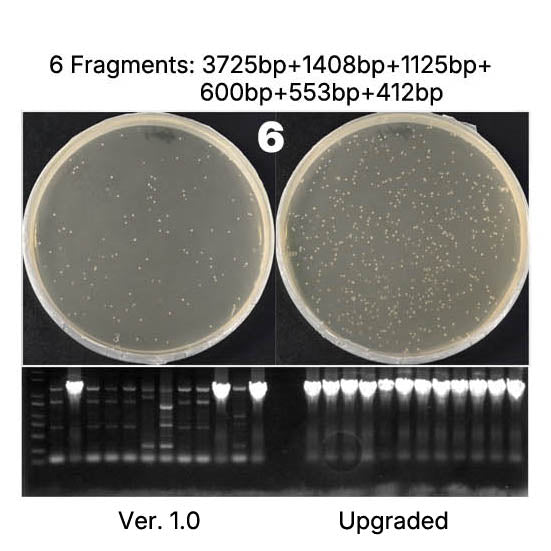
Hieff Clone ™ Universal II مجموعة استنساخ خطوة واحدة _ 10923es

فئات المنتجات
-
-
- دليل اختيار الإنزيم (32)
- بوليميريز الحمض النووي (17)
- RNA بوليميريز (5)
- نسخة عكسية (5)
- الحمض النووي/RNA ligase (7)
- نوكلياز (26)
- تعديل إنزيم (19)
- إنزيمات تقييد (28)
- مثبط RNase (4)
- إنزيم تحرير الجينات (4)
- transposase (0)
- البروتياز (16)
- جليكوسيداز (7)
- إنزيمات أخرى (1)
- الإنزيم متعدد الوظائف (0)
- وضع الإنزيم (3)
- الفوسفاتيز (2)
- الجزيئات النشطة بيولوجيًا (15)
جميع المنتجات
2783 منتجات
عرض 673 - 720 ل 2783 منتجات
عرض 673 - 720 ل 2783 منتجات
عرض
منظر
يحفظ $205.00


Yeasen
Hieff NGS ™ DNA Selection Beads Superior Ampure XP Alternative _ 12601es
سعر البيعمن $60.00
سعر منتظم$265.00
يحفظ $130.00


Yeasen
Hieff NGS ™ DNA Selection Beads Superior Ampure XP Alternative _ 12601es
سعر البيعمن $135.00
سعر منتظم$265.00
المرشحات (0)